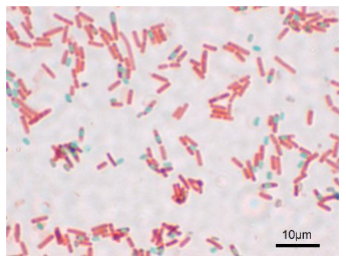
<p>What kind of stain?</p>

Lab 8: Endospore Stain
1/18
There's no tags or description
Looks like no tags are added yet.
Name | Mastery | Learn | Test | Matching | Spaced | Call with Kai |
|---|
No analytics yet
Send a link to your students to track their progress
19 Terms
What kind of stain?
endospore

What kind of Stain?
endospore
When are endospores produced?
When water and nutrients are depleted
What layers protect endospores?
Thick peptidoglycan and protein coats
What is another name for the endospore stain?
Christmas tree stain
What are the three positions of endospores in a cell?
Terminal, subterminal, and central
How long can endospores remain dormant?
Thousands of years
What is the first step in the procedure?
Make smears of the given strains
What do you do after making the smear?
Air dry
What is done after air drying?
Heat fix the smear
What is placed on top of the smear before staining?
A piece of paper towel
What stain is poured over the paper towel?
Malachite green
How long is the slide heated with malachite green?
5 minutes until steaming
What must you prevent during heating?
Do not let the slide dry
What do you remove after heating?
The paper towel
What should the slide do before rinsing?
Cool down
What is done after the slide cools?
Rinse with water
What is the counterstain used?
Safranin
How long is safranin applied?
2 minutes